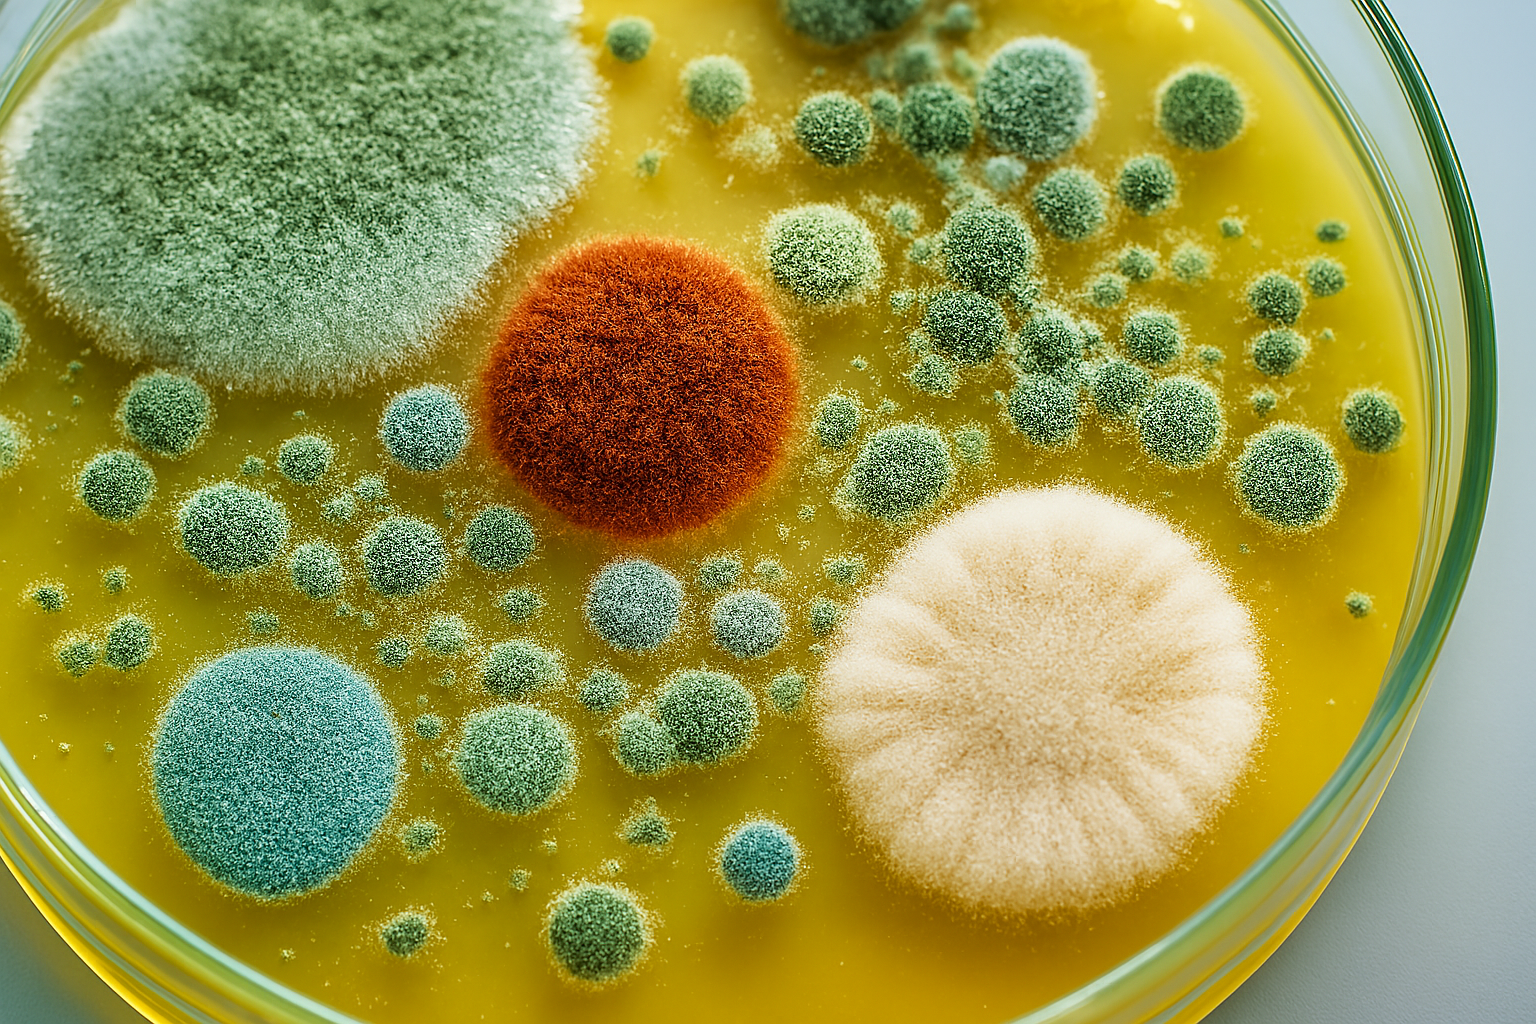

Brockville
Kingston
330 Laurier Blvd.
Ontario
K6V 7L9
+1 613 345 1991
25 Railway St.
Ontario
K7K 2L7
+1 613 546 6663
This training covers essential topics related to mould, including the various types and the ways mould can enter both workplaces and homes. The course explains the impact of mould on health and explores methods for remediation. Mould is identified as an occupational hazard for workers indoors, as well as those working outdoors in warm and humid environments. While current Occupational Health & Safety legislation does not directly address the health risks connected to mould exposure, the presence of mould growth in buildings is considered unacceptable. Certain workplaces may face particular health hazards due to mould.
• Definition of mould and what it is
• Overview of different types of mould
• Health effects associated with mould exposure
• Prevention strategies for mould growth
• Approaches to mould remediation